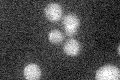

View description
Transcription elongation factor that contains a conserved zinc finger domain; implicated in the maintenance of proper chromatin structure in actively transcribed regions; deletion inhibits Brome mosaic virus (BMV) gene expression
Localization:
Intensity:
Fold change:
Significance:
-
C’ GFP library in SD
below threshold16.48 -
N' NOP1pr-GFP in SD

cell periphery,vacuole24.4586 -
N' TEF2pr-mCherry in SD

cell periphery,vacuoleN/A -
N' NATIVEpr-GFP in SD

below threshold17.9101 -
N' TEF2pr-VC and Cyto-VN in SD

#N/A0 -
C’ GFP library in SD+DTT

cytosol15.760.95No -
C’ GFP library in SD+H2O2

cytosol16.861.02No -
C’ GFP library in Starvation Media

cytosol17.881.08No -
C’ GFP library on the background of Pup2-DaMP

below threshold -
C’ GFP library on the background of CCT mutant

below threshold15.63260.948056No
